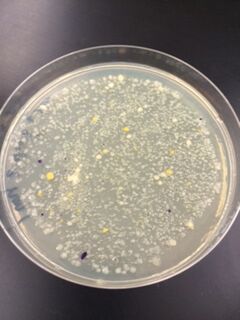
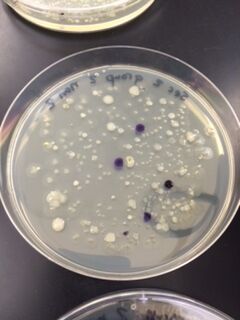
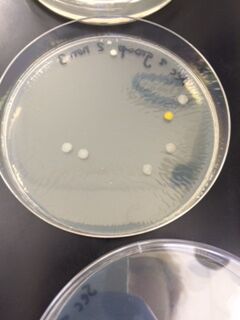
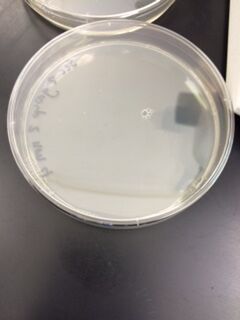
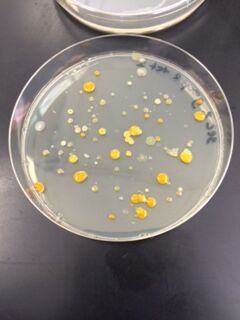
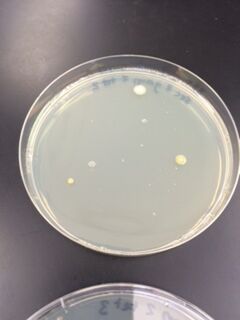
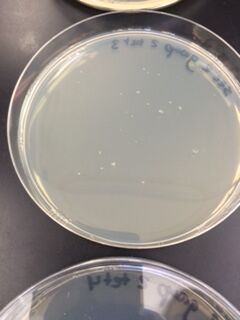
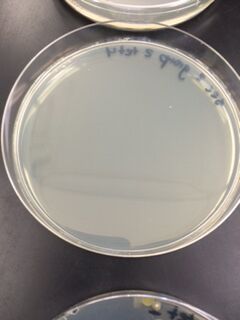

User:Corina C. Velazco/Notebook/Biology 210 at AU
PCR Sequence of Wild Life Habitat Transect: March 4, 2015
Purpose: The purpose of the 16S Sequencing is to identify the bacteria species in the Hay Infusion Culture of the Wild Life transect from the agar and agar+tetracycline plates produced during lab.
Materials and Methods: After the observation of the bacteria of the Hay Infusion Cultures, one from the agar plates and one from the agar plates with tetracycline were chosen to amplify the 16S rRNA gene. A single colony was transfered to a sterile tube that contained 100µl of water and then it was incubated in 100°C for 10 minutes and then it was centrifuged for 5 minutes at 13,400rpm. After centrifugation, 5µl of the supernatant was placed in the PCR tube that had the PCR bead and the 20µl of the primer. A week after, the the PCR products were ran on an agarose gel and then the instructors purified the DNA for sequencing. The 16S sequencing is used to identify species of bacteria. The instructors provided us with the label of the two samples chosen. A link was provided where all the sequences of all labs were in a data table and the MB# labels that pertained to the transect were given. Next, once the sequences were found, they were viewed and copied and then taken to a website to obtain the database for the matches of the sequence.
Data and Observations: The two samples that were used for the 16S sequencing were the 10^-5 dilution without tetracycline and the 10^-3 dilution with tetracycline. When the PCR products were run on an agarose gel, this is what it showed:
For the sequencing, these were labeled and MB43 (10^-5 dilution without tetracycline) and MB44 (10^-3 dilution with tetracycline). The sequences were obtained and are provided below: MB43 GGNNNNNNNNNNNNNNNNANNNTGCAGTCGTACAGGTAGCCGTAANTTGCTCTCGGGTGACGAGTGGCGGACGGGTGANT AATGTCTGGGAAACTGCCTGATGGAGGGGGATAACTACTGGAAACGGTAGCTAATACCGCATAACGTCGCAAGACCAAAG AGGGGGACCTTCGGGCCTCTTGCCATCAGATGTGCCCAGATGGGATTAGCTAGTAGGTGGGGTAATGGCTCACCTAGGCG ACGATCCCTAGCTGGTCTGAGAGGATGACCAGCCACACTGGAACTGAGACACGGTCCAGACTCCTACGGGAGGCAGCAGT GGGGAATATTGCACAATGGGCGCAAGCCTGATGCAGCCATGCCGCGTGTATGAAGAAGGCCTTCGGGTTGTAAAGTACTT TCAGCGGGGAGGAAGGTGTTGTGGTTAATAACCGCAGCAATTGACGTTACCCGCANAANAAGCACCGGCTAACTCCGTGC CAGCANCCGCGGTAATACGGANGGTGCAAGCGTTAATCGGNAATTACTGGGCGTAAAAGCGCACGCAGGCGGTCTGTCAA GTCGGATGTGAAANTCCCCCGGGCTCAACCTGGGAACTG
MB44 NNNNNNNNNNNNNNNNCNNNNNNNNGACAGCCGAGCGGTAGAGATCTTTCGGGATCTTGAGAGCGNGCGNTACGGGTGCG GANCNNNTGTGCAACCTGCCTTTATCAGGGGGATAGCCTTTCGAAAGGAAGATTAATACCCCATAATATATTGAATGGCA TCATTTGATATTGAAAACTCCGGTGGATAGAGATGGGCACGCGCAAGATTAGATAGTTGGTAGGGTAACGGCCTACCAAG TCAGTGATCTTTAGGGGGCCTGAGAGGGTGATCCCCCACACTGGTACTGAGACACGGACCAGACTCCTACGGGAGGCAGC AGTGAGGAATATTGGACAATGGGTGAGAGCCTGATCCAGCCATCCCGCGTGAAGGACGACGGCCCTATGGGTTGTAAACT TCTTTTGTATAGGGATAAACCTTTCCACGTGTGGAAAGCTGAAGGTACTATACGAATAAGCACCGGCTAACTCCGTGCCA GCAGCCGCGGTAATACGGAGGGTGCAAGCGTTATCCGGATTTATTGGGTTTAAAGGGTCCGTAGGCGGATCTGTAAGTCA GTGGTGAAATCTCATAGCTTAACTATGAAACTGCCATTGATACTGCAGGTCTTGAGTAAANGTANAAGTGGCTGGAATAA GTANTGTANCGGTGAAATGCATAGATATTACTTANAACACCNATTGCGANNCAGGTCACTATGNTTTAACTGACGCTGAT GGACGAAAGCGTGGGGAGCGAACNGGATTANATACCCTGGGTAGTCCACGCCGTAAACNATGCTAACTCGTTTTTGGNCT TTAGGGTTCAGANACTAAACNAAAGTGATNAGTTAAGCCNCCTGGGGANTACGTTCGCAAGAATGAAACTCANAGGAATT GAACGGGGGCCCGCACACCGGGGGATTATGTGGTTTANTNNNATNANTCNCANGGAACCNTACCANGCTAAATGGGNATT GANGGGTNNNNANTAGACTTTCTTCNANNNTTTCAANGNNCTNCATGGGTGGNNGNGNGCTNNNGCNNNNAAGNNNNNNN N
For the MB43 16S Sequencing, the best match of the species was Enterobacteriaceae bacterium S2A (Query cover of 96%). For the MB44 16S Sequencing, the chart provided by the instructors described it as poor quality. Although little information was provided, the closest match was Uncultured bacterium clone nbw505g01c1 (Query cover of 89%).
Conclusions: The MB43 16S Sequencing that resulted in Enterobacteriaceae bacterium S2A, corresponds to the previous observations done on the bacteria plates. This bacteria is gram negative because it does not have a thick layer of peptidoglycan ([1]). While doing the gram staining procedure during lab, this dilution of 10^-5 without tetracycline proved to be negative. Therefore this goes along with the data that has been collected thus far. On the other hand, the MB44 had poor quality which resulted in an uncultured bacterium which is not specific and does not allow for further research. This may be caused by poor pipetting skills or some other error while setting up the PCR.
CV
4.6.15 Very good. SK
Zebrafish and Embryonic Development: Lab 6 on February 25, 2015
Purpose: The purpose of performing an experiment with zebrafish is to understand the stages of embryonic development and then observe how environmental variations affect development. In this experiment, alcohol was used to observe the differences in eye diameter, heart rate and survival rate. Zebrafish are known to be important models for experiments so the effects of their development can be applied to other organisms. Alcohol was chosen to see how this affects zebrafish and by doing so conclusions can lead to future observations in humans, such as fetal alcohol syndrome. It is hypothesized that alcohol negatively affects the development of zebrafish by increasing the eye diameter, decreasing heart rate and decreasing survival rate. If the zebrafish are exposed to alcohol, then the higher concentration will have the largest impact on the zebrafish by causing abnormalities.
Methods and Materials: First, a published paper of an experiment done on zebrafish with alcohol in order to be able to develop an experiment on the zebrafish in lab. Three petri dishes were labeled and used, including the control group which is just 20mL of water. The other two experimental groups were a dilution of 0.75% of alcohol and 0.325% of alcohol. A total of 20 embryos were transfer to each petri dish with a dropper. Following the experimental set up, a schedule was established with the group in order to coordinate who would check on the zebrafish on Day 1 (February 20th) and Day 4 (February 23rd).
Data and Observations: On the day of setting up the experiment— Day 0 (February 19th)— the stage of the embryo was a dome to zygote stage. The three tables below provide the data collect up until Day 4.
Table 1: Water Only Solution
Table 2: 0.75% Dilution Alcohol
Table 3: 0.325% Dilution Alcohol
Conclusions: The data collected on Day 4 was surprising. Water had the most dead eggs and the diluted solution of 0.375% alcohol had the highest survival rate. Currently there are only a few fish and the heart rate cannot be determined yet but there is definitely a difference with the appearance of the fish. As the days continue, the zebrafish will either die or continue to develop in their environment and the data collection will continue.
4.6.15 Good start but missing data from later observations. If there was no data because zebrafish died that's fine but you need to include that. SK
2.20.15
Good description of invertebrates found in transect. A brief explanation of the Berlese funnel set-up would have helped.
Incomplete vertebrate section. No vertebrates listed and no food web.
SK
Invertebrates: Lab 5 on February 18, 2015
Purpose: The purpose of this lab is to understand the importance of how invertebrates function and how this can be assimilated to learn how complex systems are derived from simple systems. This assimilation is an example of evolution. This was done by observing invertebrate slides provided and from the invertebrates collected from the Burlese Funnel from the transect (#2).
Materials and Methods: To observe the provided slides, a dissecting scope was used in order to observe Planaria, nematodes and Annelida. Then after dismanteling the Burlese Funnel, the liquid was divided into two petri dishes and observed under a dissecting microscope in order to analyze them. Finally, the vertebrates were also considered and the species were determined using the Freeman textbook.
Data and Observations: When Planaria was observed under the dissecting microscope, their flatworm solid bodies allowed them to make a whip-like movement. The nematodes were had round bodies and their movement resembled undulations. Finally, Annelida had a fluid filled cavity, also called coelomate, moved with a rippling effect. Then when the Burlese Funnel was dismantled and the petri dishes were observed, there were three organisms found.
Beetle
Worm (Protura)
The largest of all, as shown in the graph is the worm measuring 2mm, then comes the beetle with respect to size with a measurement of 1.5mm. The smallest of them all was the spider, measuring only 0.5mm.
Vertebrates
The five vertebrates that might inhabit the Wild Life Habitat transect are the following:
These organisms all together represent a community that inhabits a wild life habitat because they are different species living together. In addition, because this wild life habitat is small, there is a maximum number of individuals of species that can inhabit in a particular system and be able to survive. Fortunately for these five species, the carrying capacity is not an issue because there is an abundance of the biotic and abiotic factors. In terms of their trophic levels, as shown below, none of them are 'on top of the food chain,' and other than the squirrels and rats that compete for food, the birds do not have to fight them because of their ability to fly and find food somewhere else.
2.20.15
Good notebook entry. Included all relevant data and gave some detailed descriptions.
SK
Plantae and Fungi: Lab 4 on February 11, 2015
Purpose: The purpose of this lab is to understand the characteristics and diversity of plants through their vascularization, specialized structures and different mechanisms of reproduction. This was done by observing the plants in the transect that has been on observation for several weeks. In addition, the importance of fungi is observed and helps appreciate the functions of different types of fungi by observing three different types.
Materials and Methods: There were five different types of plants collected from Transect #2. Back in the lab, the characteristics of a Bryophyte moss, Mnium, and an angiosperm, Lilium were observed to understand the diversity of plants. Then the five types of plants were observed the same way the previous plants were observed and were categorized as dicot or monocot, and non-vascular, seedless, gymnosperm or angiosperms. Then, in order to observe the mechanisms of reproduction and flower was dissected to observe all the parts of the life cycle. Finally, in order to appreciate fungi, different types of fungi were observed and categorized into the three divisions: Zygomycota, Basidiomycota and Ascomycota.
Data and Observations: Table 1 describes the five plants collected and their location within the transect.
Out of the five plants, only one was a non-vascular plant, the moss, but the rest did show vascularization. Sample plants 1, 4 and 5 were dicot by having vascular bundles and/or broad leaves (#5).
Berry Tree by Bench
Moss by rocks (Center)
Bushes west of Transect
Tree branch with small buds (South)
Plant growing (East)
Appreciating Fungi was s The three samples observetion with the dissecting microscope were Sporangia Rhizopus nigrican, a mushroom, and Rizopus stolonifer. The mushroom is part of the major division of Basidiomycota and the Rizopus stolonifer, the bread black mold, is a zygomycetes.
Sporangia Rhizopus nigrican
Rhizopus stolonifer (zygomycetes)
Conclusions and Future Observations: By studying the different plants in the transect, the diversity of plantae was observed and understood more in depth. Whether they were monocot or dicot, non-vascular or vascular, they all are part of the transect, an ecosystem and they manage to live together. By dissecting the flower, the different reproductive mechanisms, such as the gametophytes and the sporophytes were studied. The intricacy of the species of Plantae is of utmost awe. For future observations, some of the soil and leaf litter were collected and left in a Burlese Funnel for Lab 5 to observe Invertebrates.
2.9.15 Excellent notebook entry. Includes all important information and lots of data and observations. SK
Microbiology and Identifying Bacteria with DNA Sequences: Lab 3 on February 3, 2015
Purpose: To understand how bacteria live and their characteristics in the ecosystem, bacteria were observed under a microscope and then bacteria for the transect were observed as well. In addition, to differentiate organisms, in this case bacteria, staining techniques were used to see if bacteria from the transect was resistant to antibiotics.
Materials and Methods: First, the Hay Infusion Culture was examined for the last time, smell and appearance were observed. Then the eight agar plates were observed (4 with antibiotics and 4 without) and the colonies were quantified. Next, samples of the agar plates were taken to make wet mounts and were then observed under the microscope to see the characteristics of bacteria. Following the wet mount procedure, the gram staining procedure was done to see whether they were gram positive--which means they contain a thick layer of peptidoglycan, or negative, which means they have less peptidoglycan. The final procedure after all the observations were made was to set up a PCR for 16s sequencing. A single colony was transfer to a sterile tube that contained 100µl of water and then it was incubated in 100°C for 10 minutes and then it was centrifuged for 5 minutes at 13,400rpm. After centrifugation, 5µl of the supernatant was placed in the PCR tube that had the PCR bead and the 20µl of the primer.
Data and Observations: After learning about the Domain of Bacteria versus Archaea, it was determined that the transect would not have any Archaea species grown on the agar plates because it is not an extreme environment, such as hot springs. On the last observation of the Hay Infusion Culture, there was a significant amount of water that had evaporated and the smell was not as foul as before. It is hypothesized that the smell has changed because of the decrease of water and the diverse organisms that have continued to live in the Hay Infusion Culture and the organisms that have died. When observing the eight agar plates, the first two dilutions of each type of agar plates (the 10^-3 and 10^-5) of the one with tetracycline and the one without had the most colonies. Table 1 shows the calculations of each agar plate. Tetracycline is used to fight bacterial infections in humans, therefore, that is why there were less colonies in the first two dilutions of the agar plates with tetracycline.
The plates with antibiotic did not have as many colonies as the plates without antibiotics. This indicates that the bacteria found in the Hay Infusion do not have a strong antibiotic resistance. The agar plates that contained tetracycline did not have any purple colonies, it only had orange colonies. Following this observation, it was observed under the microscope and described using the Table 2. In addition the gram staining procedure was also conducted and as a results, the gram positive colonies were 10^-3 no tetracycline, 10^-5 no tetracycline, and 10^-3 with tetracycline because they stained blue. However, 10^-5 with tetracycline resulted as gram negative because it stained pink.
These were the agar plates without tetracycline:
Dilution 10^-3
Dilution 10^-5
Dilution 10^-7
Dilution 10^-9
These were the agar plates with tetracycline:
Dilution 10^-3
Dilution 10^-5
Dilution 10^-7
Dilution 10^-9
Conclusions and Future Observations:
By observing bacteria and antibiotic resistance, we are able to see the roles they play on Earth. Antibiotic resistance has led to disease and as a result a global public health concern. Gram staining and observing structural characteristics allow us to know how bacteria function and where they are predominantly found. In future observations, observing the genes of bacteria in the Hay Infusion Culture will help us understand what kind of bacteria live in different niches.
Sources: Tetracycline (Antibiotics) Uses, Dosage, Side Effects - Drugs.com. (n.d.). Retrieved February 4, 2015, from http://www.drugs.com/tetracycline.html
2.3.15 Excellent. Good layout and structure. Relevant images. SK
Identifying Algae and Protist: Lab 2 on January 28, 2015
Purpose: To understand how unknown organisms are identified, the dichotomous key is used after making observations about size, shape, motility and color. This is used to understand the different characteristics of unicellular eukaryotes-- protist and algae. Protist and Algae will be identified In the Hay Infusion Culture from the transect #2 that was made last week.
Materials and Methods: In order to get familiarized with how the dichotomous key works, first a wet mount of known organisms are observed under the microscope and the dichotomous key is used to identify it in order to make sure that it can be used with unknown organisms now. After successful identifying at least two known organisms, Hay Infusion Culture observations can begin, but first the culture must be observed without disturbing it. Secondly, two samples must be taken for observation from two different niches (in this case, top and bottom). A wet mount is made for each of the samples and protist and algae from the Hay Infusion Culture are identified. Finally, to prepare for Lab 3, a total of eight petri dishes will be prepared. Four of those will contain agar+tetracycline and the other four will just contain agar.
Data and Observations: After one week, the Hay Infusion Culture had a strong foul odor and water had already started to evaporate. The water was significantly muggy and the berries and a wood chip were on the top along with a layer of slime. The moss and the soil were in the bottom of the jar. The two samples of the different niches were taken from the top and the bottom of the culture. In the wet mount of the sample taken from the top, colpidium and gonium were identified. Gonium was 20µm, green color, with many disc shaped cells. Colpidium which was also found in the wet mount of the sample taken from the bottom measured 25µm. This organism was oval-shaped and colorless and exhibited motility since it was entirely covered in cilia. If the Hay Infusion "grew" for another two months, it will slowly begin to evaporate and the organisms will begin to reproduce, however the fact that the liquid is evaporating may deter the organisms from living in the jar. In addition, organisms might not be able to continue to live in their niche because there is a limited amount of nutrient supply.
Conclusions and Future Observations:
From observing the Hay Infusion Culture, clearly there are many organisms living in the different niches. In this case, protist and algae were identified, however, these unicellular eukaryotes are not the only organisms that may be present in the Hay Infusion Culture. Next week, we will be looking for bacteria in the petri dishes created after this lab.
 This is the process used for the dilutions for Lab 3.
This is the process used for the dilutions for Lab 3.
Biological Life at AU: Lab 1 on January 15, 2015
Purpose: To observe evolution through natural selection, an ecosystem, also known as a transect, at American University will be observed and analyzed. The biotic and abiotic components will be observed and then a sample from the assigned transect will be taken to examine it through the first several weeks of the semester. This is done to study the interactions that occur in a specific niche and see all the different species that live there.
Materials and Methods: First, the TA gave each student a number to have groups of three assigned to each transect. Once given the map, my group went to the transect and observed, analyzed and took the sample with a 50mL conical tube-- 50% of the soil from the transect and the other 50% consisted of moss, grass, berries and leaves. Then back in the lab a Hay Infusion Culture was made by mixing 10 grams of the sample gathered from the transect with 500mLs of deerpark water (that way there were no pollutants), and 0.1 grams of fried milk. This mixture was covered with a lid and mixed for 10 seconds and then the jar was placed in the back of the lab without the lid.
Data and Observations: The 20 by 20 meter transect that was assigned is located on the North side of campus on the side where Hughes Hall and McDowell Hall are adjacent to each other (labeled #2). Its biotic components consisted of trees, moss, bushes, grass and berries. Its abiotic, or nonliving, components consisted of rocks, occasional shade from the Hughes Hall building, benches, soil and snow.
Conclusions and Future Directions: The biotic and abiotic components in the transect affect the population living in it. By observing the niche, will help identify and learn about the species in that specific niche. The Hay Infusion Culture will be observed the following week and different species will be observed. This provides an idea of how an ecosystem provides a habitat to a diverse amount of species and also it further helps us understand the many life forms caused by evolution.
CV
1.27.15 Good first entry. Nice structure and layout. Good pictures. SK